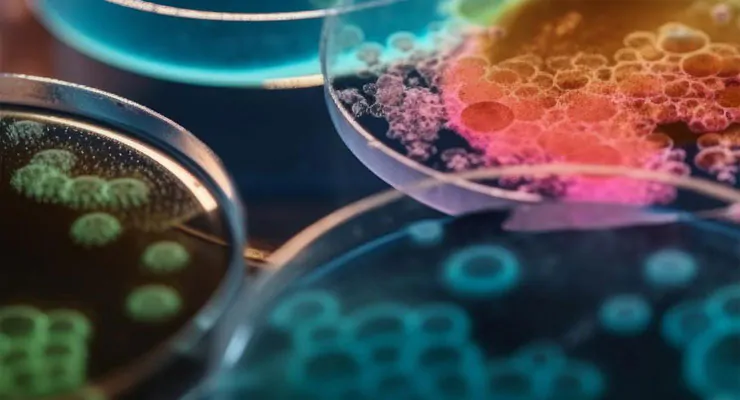

"Exceptional service and reliable lab equipment. We've improved efficiency across all departments!"
"Professional support and fast delivery. Polskie Laboratorium is our trusted partner."
"They understand what labs need. High quality, reasonable prices, and excellent communication."

/>
/>